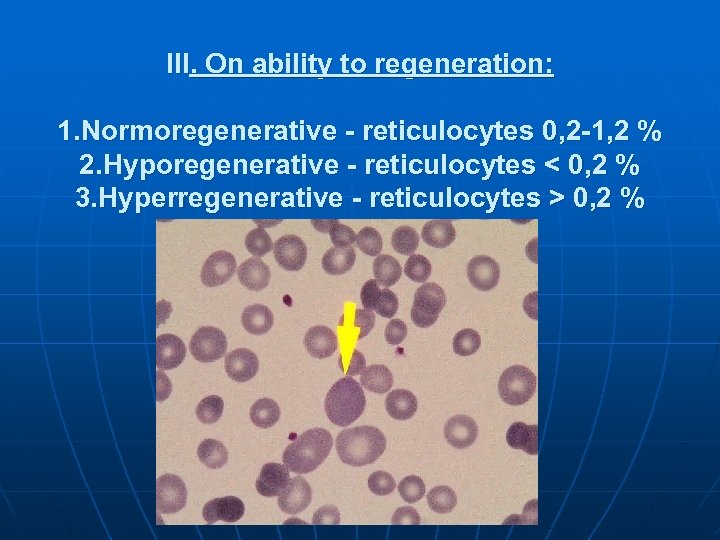
III. On ability to regeneration: 1. Normoregenerative - reticulocytes 0, 2 -1, 2 %
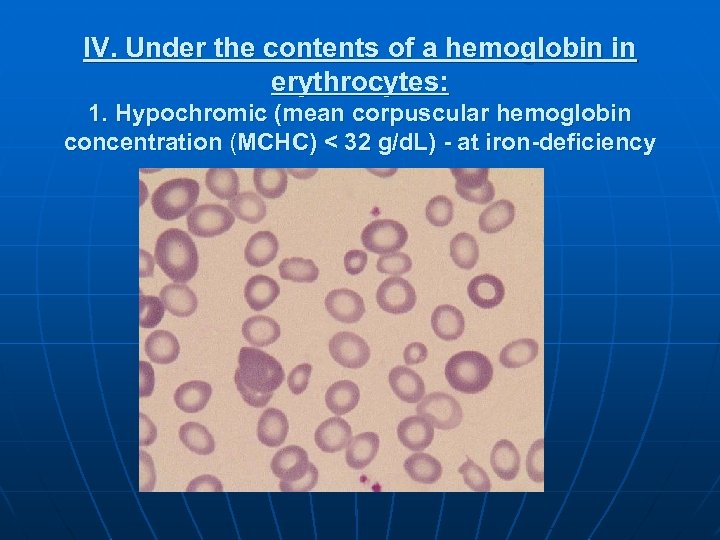
IV. Under the contents of a hemoglobin in erythrocytes: 1. Hypochromic (mean corpuscular hemoglobin
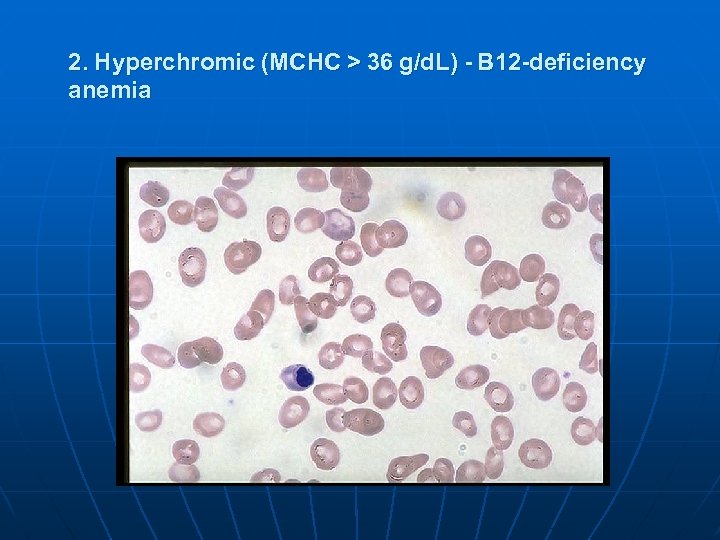
2. Hyperchromic (MCHC > 36 g/d. L) - В 12 -deficiency anemia
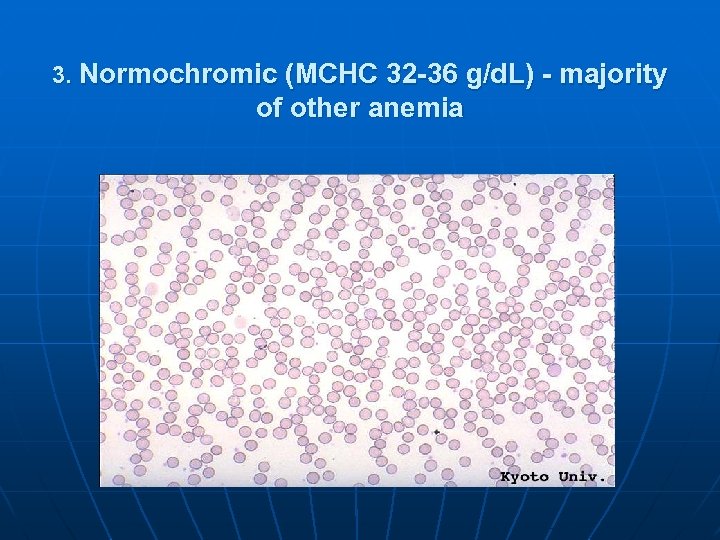
3. Normochromic (MCHC 32 -36 g/d. L) - majority of other anemia
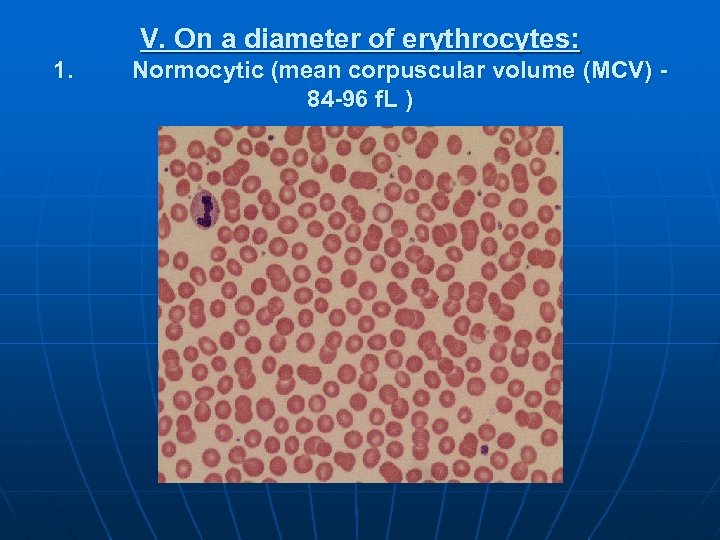
V. On a diameter of erythrocytes: 1. Normocytic (mean corpuscular volume (MCV) 84 -96
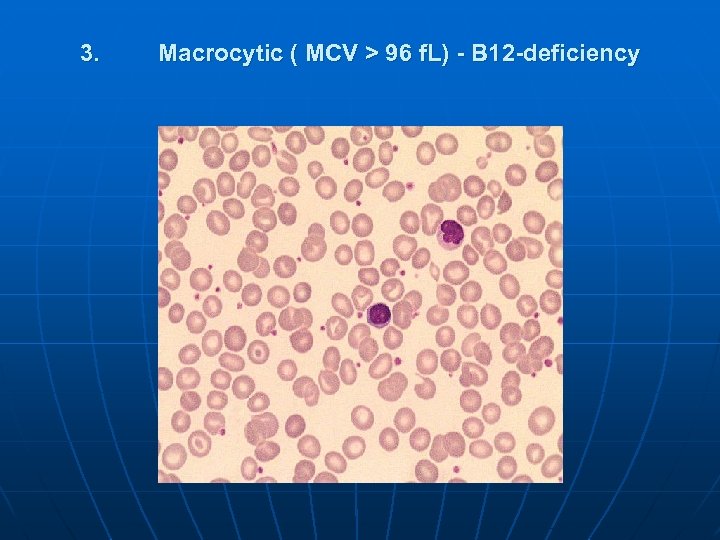
3. Macrocytic ( MCV > 96 f. L) - В 12 -deficiency
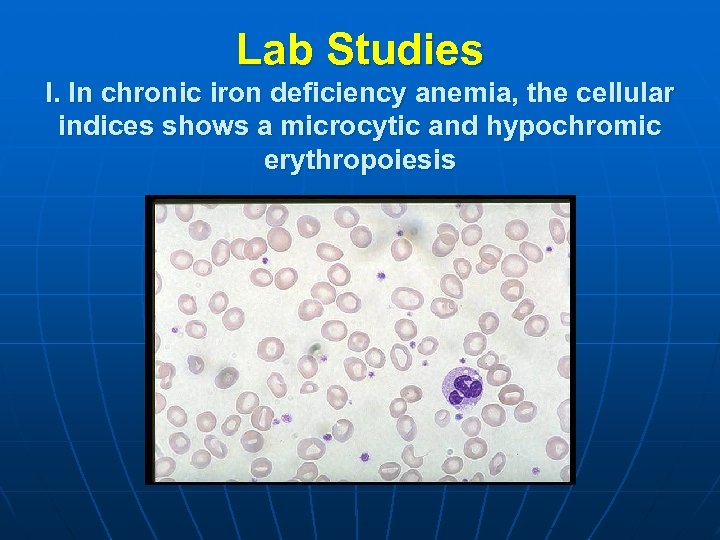
Lab Studies I. In chronic iron deficiency anemia, the cellular indices shows a microcytic
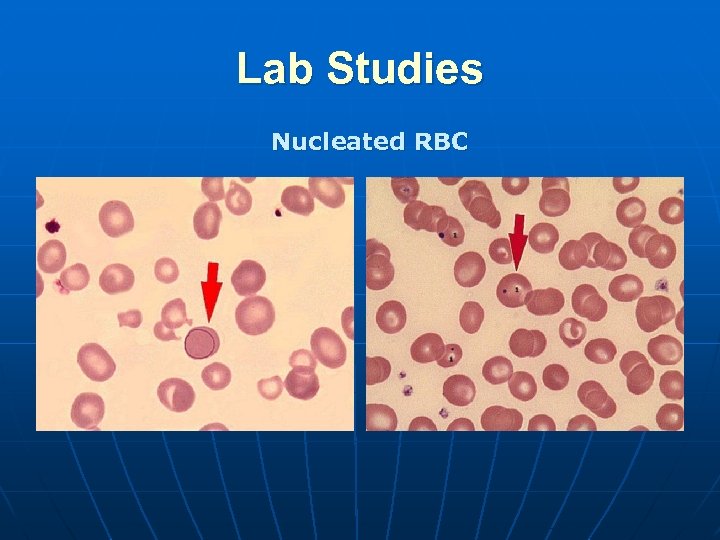
Lab Studies Nucleated RBC

8f11373736adcdc581c18819a40c0f10.ppt
- Количество слайдов: 61
 THE MAIN HAEMATOLOGICAL SYNDROMES Krynytska I. Ya.
THE MAIN HAEMATOLOGICAL SYNDROMES Krynytska I. Ya.
 Anemia - decrease in level of hemoglobin and red blood cell (RBC) mass. n Anemic syndrome is combination of laboratory signs of an anemia and its clinical manifestations caused by a hypoxia and a hypoxemia n
Anemia - decrease in level of hemoglobin and red blood cell (RBC) mass. n Anemic syndrome is combination of laboratory signs of an anemia and its clinical manifestations caused by a hypoxia and a hypoxemia n
 Anemic syndrome Complaints n General: weaknesses, fatigue, dizziness, syncopal and orthostatic condition, decrease of memory. n From the cardiovascular system: a dyspnoe, palpitation; in case of presence coronary artery disease worsening of its symtoms.
Anemic syndrome Complaints n General: weaknesses, fatigue, dizziness, syncopal and orthostatic condition, decrease of memory. n From the cardiovascular system: a dyspnoe, palpitation; in case of presence coronary artery disease worsening of its symtoms.
 Anemic syndrome Physical examination n at external medical examination - pallor; n from the cardiovascular system: a tachycardia, systolic murmur above an apex cordis
Anemic syndrome Physical examination n at external medical examination - pallor; n from the cardiovascular system: a tachycardia, systolic murmur above an apex cordis
 Laboratory methods The World Health Organization's criterion for anemia in adults is Hb values less than 12. 5 g/d. L. Usually, US values are slightly higher. Anemia is suggested in males with Hb levels less than 13. 5 g/d. L and in females with Hb levels less than 12. 5 g/d. L.
Laboratory methods The World Health Organization's criterion for anemia in adults is Hb values less than 12. 5 g/d. L. Usually, US values are slightly higher. Anemia is suggested in males with Hb levels less than 13. 5 g/d. L and in females with Hb levels less than 12. 5 g/d. L.
 Classification of anemia І. Pathogenetic: 1. As a result of loss of erythrocytes during the bleeding (acute and chronic posthemorrhagic anemia); 2. As a result of increase destruction of erythrocytes (hemolytic anemia); 3. As a result of the broken synthesis of hemoglobin (iron-deficiency) and maturing of erythrocytes (megaloblastic and aplastic anemia).
Classification of anemia І. Pathogenetic: 1. As a result of loss of erythrocytes during the bleeding (acute and chronic posthemorrhagic anemia); 2. As a result of increase destruction of erythrocytes (hemolytic anemia); 3. As a result of the broken synthesis of hemoglobin (iron-deficiency) and maturing of erythrocytes (megaloblastic and aplastic anemia).
 Classification of anemia II. By a degree of severity: 1. Easy - decrease Hb on 5 -19, 9 % from initial 2. Average - on 20 -39, 9 % 3. Heavy - more than on 40 % The decrease Hb up to 5 % is considered as norm
Classification of anemia II. By a degree of severity: 1. Easy - decrease Hb on 5 -19, 9 % from initial 2. Average - on 20 -39, 9 % 3. Heavy - more than on 40 % The decrease Hb up to 5 % is considered as norm
III. On ability to regeneration: 1. Normoregenerative - reticulocytes 0, 2 -1, 2 % 2. Hyporegenerative - reticulocytes < 0, 2 % 3. Hyperregenerative - reticulocytes > 0, 2 %
III. On ability to regeneration: 1. Normoregenerative - reticulocytes 0, 2 -1, 2 % 2. Hyporegenerative - reticulocytes < 0, 2 % 3. Hyperregenerative - reticulocytes > 0, 2 %
IV. Under the contents of a hemoglobin in erythrocytes: 1. Hypochromic (mean corpuscular hemoglobin concentration (MCHC) < 32 g/d. L) - at iron-deficiency
IV. Under the contents of a hemoglobin in erythrocytes: 1. Hypochromic (mean corpuscular hemoglobin concentration (MCHC) < 32 g/d. L) - at iron-deficiency
2. Hyperchromic (MCHC > 36 g/d. L) - В 12 -deficiency anemia
2. Hyperchromic (MCHC > 36 g/d. L) - В 12 -deficiency anemia
3. Normochromic (MCHC 32 -36 g/d. L) - majority of other anemia
3. Normochromic (MCHC 32 -36 g/d. L) - majority of other anemia
V. On a diameter of erythrocytes: 1. Normocytic (mean corpuscular volume (MCV) 84 -96 f. L )
V. On a diameter of erythrocytes: 1. Normocytic (mean corpuscular volume (MCV) 84 -96 f. L )
 2. Microcytic (MCV < 84 f. L ) - iron-deficiency, hemolytic anaemia
2. Microcytic (MCV < 84 f. L ) - iron-deficiency, hemolytic anaemia
3. Macrocytic ( MCV > 96 f. L) - В 12 -deficiency
3. Macrocytic ( MCV > 96 f. L) - В 12 -deficiency
 Sideropenic syndromes From the skin covers, appendages of a skin and mucous membranes: - dryness of a skin, - fragility of a hair fragility and banding nails, they become flat, sometimes accept the concave form (koilonychias); 1.
Sideropenic syndromes From the skin covers, appendages of a skin and mucous membranes: - dryness of a skin, - fragility of a hair fragility and banding nails, they become flat, sometimes accept the concave form (koilonychias); 1.
 Sideropenic syndromes 2. From the gastrointestinal tract: - decrease and distortion of appetite, - dysphagy, - constipations or diarrhea, - glossitis, burning of tongue, - esophagitis; -
Sideropenic syndromes 2. From the gastrointestinal tract: - decrease and distortion of appetite, - dysphagy, - constipations or diarrhea, - glossitis, burning of tongue, - esophagitis; -
 Sideropenic syndromes unusual predilections for some smells - acetone, petrol; - angular stomatitis; - the distortion of taste as desire is a chalk, tooth paste, ashes, paint; - abnormality of a swallowing with sensation of an alien body in a throat. -
Sideropenic syndromes unusual predilections for some smells - acetone, petrol; - angular stomatitis; - the distortion of taste as desire is a chalk, tooth paste, ashes, paint; - abnormality of a swallowing with sensation of an alien body in a throat. -
 Causes of development of iron-deficiency states: n n n Blood loss Vegetarians Prolonged achlorhydria Extensive surgical removal of the proximal small bowel or chronic diseases, such as pancreatitis, enteritis. Increased iron requirement: From birth to age 2 and during adolescence During pregnancy and lactation
Causes of development of iron-deficiency states: n n n Blood loss Vegetarians Prolonged achlorhydria Extensive surgical removal of the proximal small bowel or chronic diseases, such as pancreatitis, enteritis. Increased iron requirement: From birth to age 2 and during adolescence During pregnancy and lactation
Lab Studies I. In chronic iron deficiency anemia, the cellular indices shows a microcytic and hypochromic erythropoiesis
Lab Studies I. In chronic iron deficiency anemia, the cellular indices shows a microcytic and hypochromic erythropoiesis
 Lab Studies n n n Decrease of iron concentration. Normal serum iron is 13 to 27 μmol/L for men and 11 to 25 μmol/L for women. Increase of iron-binding capacity. Total iron-binding capacity is 45 to 81 μmol/L. Decrease of serum ferritin. The range of normal in most laboratories is 30 to 300 ng/m.
Lab Studies n n n Decrease of iron concentration. Normal serum iron is 13 to 27 μmol/L for men and 11 to 25 μmol/L for women. Increase of iron-binding capacity. Total iron-binding capacity is 45 to 81 μmol/L. Decrease of serum ferritin. The range of normal in most laboratories is 30 to 300 ng/m.
 Lab Studies Decrease of sideroblasts in the bone marrow aspirate. Normally, ther are 20 to 40% sideroblasts.
Lab Studies Decrease of sideroblasts in the bone marrow aspirate. Normally, ther are 20 to 40% sideroblasts.
 Megaloblastic anemia n n n The molecular basis for megaloblastosis is a failure in the synthesis and assembly of DNA. The most common causes of megaloblastosis are cobalamin and folate deficiencies. Prevalence of megaloblastosis is enlarged with the years and makes up at young persons about 0, 1 %, at elderly up to 1 %. Women are sick more often.
Megaloblastic anemia n n n The molecular basis for megaloblastosis is a failure in the synthesis and assembly of DNA. The most common causes of megaloblastosis are cobalamin and folate deficiencies. Prevalence of megaloblastosis is enlarged with the years and makes up at young persons about 0, 1 %, at elderly up to 1 %. Women are sick more often.
 Pathophysiology n n Dietary intake (meat, liver, kidneys, eggs, milk, cheese, beans) is the source of cobalamin and folate because humans cannot synthesize these substances. Cobalamin must be bound to intrinsic factor, and this complex is taken up in the terminal ileum.
Pathophysiology n n Dietary intake (meat, liver, kidneys, eggs, milk, cheese, beans) is the source of cobalamin and folate because humans cannot synthesize these substances. Cobalamin must be bound to intrinsic factor, and this complex is taken up in the terminal ileum.
 Pathophysiology n Cobalamin enzymes - metabolism of nucleic acids, and at its deficiency mitotic processes in fast -growing tissues (a bone marrow, an epithelium of a GI tract) are broken, - exchange of fat acids, synthesis and neogeneses of a myelin, and at its disadvantage these processes are broken. Also a defect in adenosylcobalamin-dependent conversion of methylmalonyl coenzyme A to succinyl coenzyme A exists.
Pathophysiology n Cobalamin enzymes - metabolism of nucleic acids, and at its deficiency mitotic processes in fast -growing tissues (a bone marrow, an epithelium of a GI tract) are broken, - exchange of fat acids, synthesis and neogeneses of a myelin, and at its disadvantage these processes are broken. Also a defect in adenosylcobalamin-dependent conversion of methylmalonyl coenzyme A to succinyl coenzyme A exists.
 Causes of cobalamin deficiency n n n n Nutritional deficiency Food-cobalamin malabsorption (gastric anacidity) Absence of functional intrinsic factor Severe abnormalities in the terminal ileum due to ileal resection, regional ileitis, or lymphoma Helminthic invasion Blind loop syndrome Drugs • Cytostatics • Anticonvulsants • Oral contraceptives • Nonsteroid antiinflamatory drugs • Some antidiabetic drugs • Colchicine
Causes of cobalamin deficiency n n n n Nutritional deficiency Food-cobalamin malabsorption (gastric anacidity) Absence of functional intrinsic factor Severe abnormalities in the terminal ileum due to ileal resection, regional ileitis, or lymphoma Helminthic invasion Blind loop syndrome Drugs • Cytostatics • Anticonvulsants • Oral contraceptives • Nonsteroid antiinflamatory drugs • Some antidiabetic drugs • Colchicine
 Clinical features 1. 2. 3. Anemic syndrome Jaundice Gastrointestinal manifestations: anorexia; diarrhea;
Clinical features 1. 2. 3. Anemic syndrome Jaundice Gastrointestinal manifestations: anorexia; diarrhea;
 Clinical features sore tongue, which on inspection will be smooth and beefy red
Clinical features sore tongue, which on inspection will be smooth and beefy red
 Clinical features 4. Neurologic manifestations: numbness and paresthesia in the extremities; weakness; ataxia; sphincter disturbances; diminished or increased of reflexes; positive the Romberg and Babinski’s signs; diminish position and vibration senses; disturbances of mentation
Clinical features 4. Neurologic manifestations: numbness and paresthesia in the extremities; weakness; ataxia; sphincter disturbances; diminished or increased of reflexes; positive the Romberg and Babinski’s signs; diminish position and vibration senses; disturbances of mentation
 Lab Studies n n macrocytosis fully hemoglobinized erythrocytes neutrophils show hypersegmentation of the nucleus leukocyte and platelet count may be decreased
Lab Studies n n macrocytosis fully hemoglobinized erythrocytes neutrophils show hypersegmentation of the nucleus leukocyte and platelet count may be decreased
Lab Studies Nucleated RBC
Lab Studies Nucleated RBC
 Lab Studies n n Decrease serum cobalamin level. The normal range is 300 to 900 pg/ml. Bone marrow aspirate is hypercellular with a decreased myeloid/erythroid ratio. Megaloblastic RBC precursors are abnormally large and have nuclei that appear much less mature than would be expected from the development of the cytoplasm (nuclear-cytoplasmic asynchrony). The nuclear chromatin is more dispersed than expected, and it condenses in a peculiar fenestrated pattern. Abnormal mitoses may be seen.
Lab Studies n n Decrease serum cobalamin level. The normal range is 300 to 900 pg/ml. Bone marrow aspirate is hypercellular with a decreased myeloid/erythroid ratio. Megaloblastic RBC precursors are abnormally large and have nuclei that appear much less mature than would be expected from the development of the cytoplasm (nuclear-cytoplasmic asynchrony). The nuclear chromatin is more dispersed than expected, and it condenses in a peculiar fenestrated pattern. Abnormal mitoses may be seen.
 Lab Studies
Lab Studies
 Lab Studies n n Increase in unconjugated bilirubin and lactic acid dehydrogenase in plasma Abdominal x-ray films, upper and lower GI series, and CT scans
Lab Studies n n Increase in unconjugated bilirubin and lactic acid dehydrogenase in plasma Abdominal x-ray films, upper and lower GI series, and CT scans
 Hemolytic Anemias n group of the diseases are characterized by raised intracorpuscular (in cells of cytophagous system) or extracorpuscular (in a vascular channel) destruction (hemolysis) of erythrocytes and decrease of duration their life (less than 120 days).
Hemolytic Anemias n group of the diseases are characterized by raised intracorpuscular (in cells of cytophagous system) or extracorpuscular (in a vascular channel) destruction (hemolysis) of erythrocytes and decrease of duration their life (less than 120 days).
 Classification
Classification
 Clinical and laboratory signs of hemolysis n n n an anemic syndrome with a normochromal anemia; a reticulocytosis; a jaundice of a skin and mucosae; hepato- and splenomegaly; augmentation of the urobilinogen content in urine; augmentation of the stercobilinogen content in a feces; level of unconjugated bilirubin elevates; low or absent levels of serum haptoglobin; rising of a level serum iron; the life span of RBC may be shortened; erythroid hyperplasia of the bone marrow.
Clinical and laboratory signs of hemolysis n n n an anemic syndrome with a normochromal anemia; a reticulocytosis; a jaundice of a skin and mucosae; hepato- and splenomegaly; augmentation of the urobilinogen content in urine; augmentation of the stercobilinogen content in a feces; level of unconjugated bilirubin elevates; low or absent levels of serum haptoglobin; rising of a level serum iron; the life span of RBC may be shortened; erythroid hyperplasia of the bone marrow.
 Acquired hemolytic anemia
Acquired hemolytic anemia
 Causes of immunohemolytic anemia
Causes of immunohemolytic anemia
 Clinical manifistations n n n anemia, spherocytosis, splenomegaly, venous thrombosis, positive direct Coombs test
Clinical manifistations n n n anemia, spherocytosis, splenomegaly, venous thrombosis, positive direct Coombs test
 Aplastic anemia n is a bone marrow failure syndrome characterized by peripheral pancytopenia and marrow hypoplasia.
Aplastic anemia n is a bone marrow failure syndrome characterized by peripheral pancytopenia and marrow hypoplasia.
 Epidemiology n n n The incidence of acquired aplastic anemia in Europe and Israel is 2 cases per million persons annually. In Thailand China, rates of 5 to 7 per million have been established. In general, men and women are affected with equal frequency, but there is a biphasic age distribution, with the major peak in the teens and twenties and a second rise in the elderly.
Epidemiology n n n The incidence of acquired aplastic anemia in Europe and Israel is 2 cases per million persons annually. In Thailand China, rates of 5 to 7 per million have been established. In general, men and women are affected with equal frequency, but there is a biphasic age distribution, with the major peak in the teens and twenties and a second rise in the elderly.
 Classification and etiology
Classification and etiology
 Drugs and chemicals associaed with aplastic anemia
Drugs and chemicals associaed with aplastic anemia
 Clinical manifestations n n n Anemic syndrome Hemorrhagic syndrome bleedings (nasal, uterine, gastrointestinal), ecchymoses and petechias Syndrome of infectious complications.
Clinical manifestations n n n Anemic syndrome Hemorrhagic syndrome bleedings (nasal, uterine, gastrointestinal), ecchymoses and petechias Syndrome of infectious complications.
 Lab studies n n A paucity of platelets, red blood cells, granulocytes, monocytes, and reticulocytes Bone marrow aspirate from iliac crest mainly fat under the microscope, with hematopoietic cells occupying less then 25% of the marrow space
Lab studies n n A paucity of platelets, red blood cells, granulocytes, monocytes, and reticulocytes Bone marrow aspirate from iliac crest mainly fat under the microscope, with hematopoietic cells occupying less then 25% of the marrow space
 Bone marrow aspirate from iliac crest Normal Aplastic anemia
Bone marrow aspirate from iliac crest Normal Aplastic anemia
 Hemorrhagic syndrome n Hemorrhagic spots on surface of the skin, patechiae, purpura, heleangiectasis, and hemorrhages. These signs are present not only on the skin, but in subcutaneous fat, muscle, brain too. The hemorrhagic syndrome is usual in case of inherited thrombocytopenic purpuras, neonatal thrombocytopenic purpuras. The other signs of this syndrome are bleeding, hematuria, upper and lower gastrointestinal tract hemorrhage, prolonged bleeding from the umbilical stump or from veni-punctures, intracranial hemorrhage.
Hemorrhagic syndrome n Hemorrhagic spots on surface of the skin, patechiae, purpura, heleangiectasis, and hemorrhages. These signs are present not only on the skin, but in subcutaneous fat, muscle, brain too. The hemorrhagic syndrome is usual in case of inherited thrombocytopenic purpuras, neonatal thrombocytopenic purpuras. The other signs of this syndrome are bleeding, hematuria, upper and lower gastrointestinal tract hemorrhage, prolonged bleeding from the umbilical stump or from veni-punctures, intracranial hemorrhage.




 Myelodysplastic syndromes n n are a diverse collection of hematological (blood-related) medical conditions that involve ineffective production (or dysplasia) of the myeloid class of blood cells. Patients with MDS often develop severe anemia and require frequent blood transfusions.
Myelodysplastic syndromes n n are a diverse collection of hematological (blood-related) medical conditions that involve ineffective production (or dysplasia) of the myeloid class of blood cells. Patients with MDS often develop severe anemia and require frequent blood transfusions.
 n The median age at diagnosis of a MDS is between 60 and 75 years; a few patients are younger than 50; MDS diagnoses are rare in children. Males are slightly more commonly affected than females. Signs and symptoms are nonspecific and generally related to the blood cytopenias:
n The median age at diagnosis of a MDS is between 60 and 75 years; a few patients are younger than 50; MDS diagnoses are rare in children. Males are slightly more commonly affected than females. Signs and symptoms are nonspecific and generally related to the blood cytopenias:
 n n n Anemia—chronic tiredness, shortness of breath, chilled sensation, sometimes chest pain Neutropenia (low neutrophil count) — increased susceptibility to infection Thrombocytopenia (low platelet count) —increased susceptibility to bleeding and ecchymosis (bruising ), as well as subcutaneoushemorrhaging resulting in purpura or petechia
n n n Anemia—chronic tiredness, shortness of breath, chilled sensation, sometimes chest pain Neutropenia (low neutrophil count) — increased susceptibility to infection Thrombocytopenia (low platelet count) —increased susceptibility to bleeding and ecchymosis (bruising ), as well as subcutaneoushemorrhaging resulting in purpura or petechia
 n n Many individuals are asymptomatic, and blood cytopenia or other problems are identified as a part of a routine blood count: neutropenia, anemia and thrombocytopenia (l ow cell counts of white and red blood cells, and platelets, respectively); splenomegaly or rarely hepatomegaly; abnormal granules in cells, abnormal nuclear shape and size; and/or chromosomal abnormalities, including chromosomal translocations and abnormal chromosome number.
n n Many individuals are asymptomatic, and blood cytopenia or other problems are identified as a part of a routine blood count: neutropenia, anemia and thrombocytopenia (l ow cell counts of white and red blood cells, and platelets, respectively); splenomegaly or rarely hepatomegaly; abnormal granules in cells, abnormal nuclear shape and size; and/or chromosomal abnormalities, including chromosomal translocations and abnormal chromosome number.

 n Blood smear from an adult female with a myelodysplastic syndrome related to radiotherapy and chemotherapy for Hodgkin disease. A hypogranular neutrophil with a pseudo-Pelger-Huet nucleus is shown. The red blood cells show marked poikilocytosis, in part related to postsplenectomy status.
n Blood smear from an adult female with a myelodysplastic syndrome related to radiotherapy and chemotherapy for Hodgkin disease. A hypogranular neutrophil with a pseudo-Pelger-Huet nucleus is shown. The red blood cells show marked poikilocytosis, in part related to postsplenectomy status.
 A typical investigation includes: n Full blood count and examination of blood film. The blood film morphology can provide clues about hemolytic anemia, clumping of theplatelets leading to spurious thrombocytopenia, or leukemia.
A typical investigation includes: n Full blood count and examination of blood film. The blood film morphology can provide clues about hemolytic anemia, clumping of theplatelets leading to spurious thrombocytopenia, or leukemia.
 n Blood tests to eliminate other common causes of cytopenias, such as lupus, hepatitis, B 12, folate, or other vitamin deficiencies, renal failure or heart failure, HIV, hemolytic anemia, monoclonal gammopathy. Age-appropriate cancer screening should be considered for all anemic patients.
n Blood tests to eliminate other common causes of cytopenias, such as lupus, hepatitis, B 12, folate, or other vitamin deficiencies, renal failure or heart failure, HIV, hemolytic anemia, monoclonal gammopathy. Age-appropriate cancer screening should be considered for all anemic patients.
 n Bone marrow examination by a hematopathologist. This is required to establish the diagnosis, since all hematopathologists consider dysplastic marrow the key feature of myelodysplasia.
n Bone marrow examination by a hematopathologist. This is required to establish the diagnosis, since all hematopathologists consider dysplastic marrow the key feature of myelodysplasia.
 n n Cytogenetics or chromosomal studies. This is ideally performed on the bone marrow aspirate. Conventional cytogenetics requires a fresh specimen, since live cells are induced to enter metaphase to enhance chromosomal staining. Flow cytometry is helpful to establish the presence of any lymphoproliferative disorder in the marrow.
n n Cytogenetics or chromosomal studies. This is ideally performed on the bone marrow aspirate. Conventional cytogenetics requires a fresh specimen, since live cells are induced to enter metaphase to enhance chromosomal staining. Flow cytometry is helpful to establish the presence of any lymphoproliferative disorder in the marrow.


